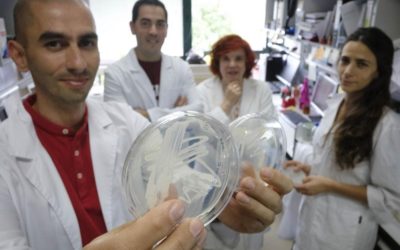
Bacterias vivas para nutrir a la reina de la primavera

Grupo Interacciones Microbianas
Investigación
Grupo de excelencia de Castilla y León
Nosotros
¿Quiénes somos y cómo trabajamos?
Nuestra línea general de investigación refleja el interés actual del grupo en estudiar la biodiversidad microbiana y analizar el potencial de los microorganismos para ser aplicados en diversas facetas biotecnológicas, con especial énfasis en el empleo de bacterias y hongos en la mejora de procesos agroalimentarios y de sostenibilidad ambiental y en la obtención de bioproductos.
Miembros del grupo de investigación
Líneas de trabajo
Actividades de divulgación científica
Noticias
Sección de noticias
De forma periódica se publican noticias de carácter científico y divulgativo relacionadas con el grupo de investigación.
Noticias
Bacterias vivas para nutrir a la reina de la primavera
Investigadores salmantinos crean un biofertilizante que logra que la fresa tenga un mayor contenido en vitaminas y antioxidantes / Una empresa se ha interesado por la explotación del proyecto. Es la reina de la primavera. Sobresale entre los frutos rojos y enamora...
El Premio Nobel Phillip Sharp inaugura el Congreso IPAP18
Durante su discurso, el académico aseguró que el movimiento anti vacunas es “muy peligroso” y habló de la importancia de la ciencia fundamental en la medicina aplicada para mejorar la vida de los pacientes. El Premio Nobel en Medicina y Fisiología...
Científicos de Salamanca descubren en un escarabajo una nueva bacteria con potencial biosanitario
Hace un par de meses, la Organización Mundial de la Salud (OMS) publicó la primera lista de patógenos resistentes a los antibióticos, que incluye las 12 familias de bacterias consideradas muy peligrosas para la salud humana. La OMS dio así la voz de alarma...
Dirección
Raúl Rivas: raulrg@usal.es